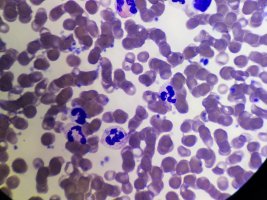
Immunologia po akademicku - konsultacje dla licealistów za nami Immunologia po akademicku - konsultacje dla licealistów za nami

Podczas zajęć w Zakładzie Immunologii w dniu 22 marca 2022 przybliżyliśmy, zarówno morfologię, jak i funkcje poszczególnych populacji komórek układu odpornościowego, uczestniczących w odpowiedzi przeciw patogenom. W części warsztatowej każdy z uczestników mógł dokonać mikroskopowej oceny morfologicznej komórek immunokompetentnych obecnych we krwi obwodowej. Ponadto miał także możliwość obserwacji w preparatach mikroskopowych takich procesów jak: chemotaksja, fagocytoza, wybuch oddechowy, czy proliferacja leukocytów.
Zajęcia przeprowadziła dr Agnieszka Iwaniuk z Zakładu Immunologii.
Materiały edukacyjne z w/w konsultacji.
Rejestracja dostępna ze strony Projektu w zakładce konsultacje
Więcej informacji o projekcie Biologia i Chemia po akademicku
Głównym celem projektu „Biologia i Chemia po akademicku” jest ukazanie praktycznego zastosowania nauki. Pragniemy, aby biologia i chemia, przedmioty, które kojarzą się uczniom z wiedzą teoretyczną zdobywaną w celu uzyskania dobrych wyników na egzaminie maturalnym, stały się realnym zainteresowaniem, które młodzież chciałaby rozwijać na studiach. Warsztaty, w których uczniowie biorą aktywny udział ukazują praktyczne zastosowanie zdobywanej przez nich w szkole wiedzy. Celem organizacji konsultacji z ekspertami na poziomie akademickim jest danie uczniom możliwości rozwinięcia tematów, które ich ciekawią, a których z różnych względów nie mają możliwości rozwinięcia w szkole.
Nasze działania dają możliwość bezpłatnego zgłębienia nauk medycznych, ale w sposób ciekawy, polegający na doświadczeniach. Wartością dodaną jest poznanie przez uczniów specyfiki pracy w zawodach medycznych.


DOFINANSOWANO ZE ŚRODKÓW BUDŻETU PAŃSTWA
PROGRAM SPOŁECZNA ODPOWIEDZIALNOŚĆ NAUKI - POPULARYZACJA NAUKI I PROMOCJA SPORTU MINISTRA EDUKACJI I NAUKI
Biologia i Chemia po akademicku
DOFINANSOWANIE
40 000 zł
CAŁKOWITA WARTOŚĆ
45 000 zł

_m.jpg)